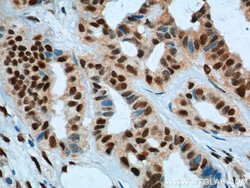
KPNA6 Rabbit anti-Human, Polyclonal, Proteintech 150 &mu;L; Unconjugated:Antibodies,

missing translation for 'onlineSavingsMsg'
Learn More
Learn More
KPNA6 Rabbit anti-Human, Polyclonal, Proteintech
Rabbit Polyclonal Antibody
Brand: Proteintech 12366-2-AP-150UL
This item is not returnable.
View return policy
Description
Nucleocytoplasmic transport, a signal- and energy-dependent process, takes place through nuclear pore complexes embedded in the nuclear envelope. The import of proteins containing a nuclear localization signal requires the NLS import receptor, a heterodimer of importin alpha and beta subunits also known as karyopherins. Importin alpha binds the NLS-containing cargo in the cytoplasm and importin beta docks the complex at the cytoplasmic side of the nuclear pore complex. In the presence of nucleoside triphosphates and the small GTP binding protein Ran, the complex moves into the nuclear pore complex and the importin subunits dissociate. Importin alpha enters the nucleoplasm with its passenger protein and importin beta remains at the pore. The protein encoded by this gene is a member of the importin alpha family.Specifications
| KPNA6 | |
| Polyclonal | |
| Unconjugated | |
| KPNA6 | |
| Importin subunit alpha 7, IPOA7, Karyopherin subunit alpha 6, KPNA6 | |
| Rabbit | |
| Antigen Affinity Chromatography | |
| RUO | |
| 23633 | |
| -20°C | |
| Liquid |
| Immunohistochemistry (Paraffin), Western Blot | |
| 0.19 mg/mL | |
| PBS with 50% glycerol and 0.1% sodium azide; pH 7.3 | |
| O60684 | |
| KPNA6 | |
| KPNA6 Fusion Protein Ag3040 | |
| 150 μL | |
| Primary | |
| Human | |
| Antibody | |
| IgG |
Product Content Correction
Your input is important to us. Please complete this form to provide feedback related to the content on this product.
Product Title
Spot an opportunity for improvement?Share a Content Correction